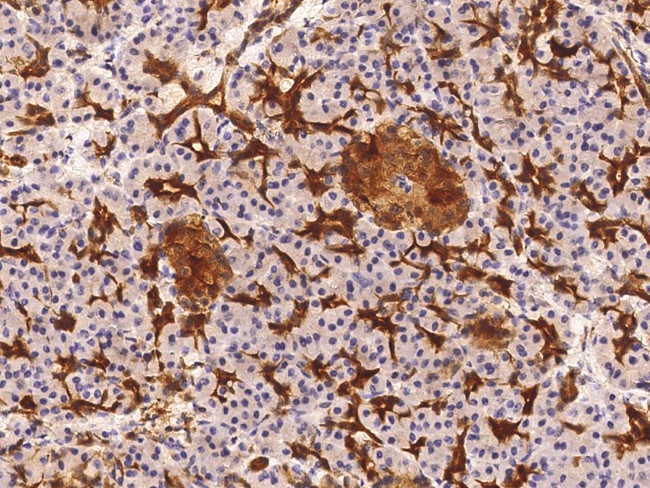
NSE Antibody in Immunohistochemistry (Paraffin) (IHC (P))

Search
Invitrogen
NSE Monoclonal Antibody (04)
{{$productOrderCtrl.translations['antibody.pdp.commerceCard.promotion.promotions']}}
{{$productOrderCtrl.translations['antibody.pdp.commerceCard.promotion.viewpromo']}}
{{$productOrderCtrl.translations['antibody.pdp.commerceCard.promotion.promocode']}}: {{promo.promoCode}} {{promo.promoTitle}} {{promo.promoDescription}}. {{$productOrderCtrl.translations['antibody.pdp.commerceCard.promotion.learnmore']}}


Please note: We are reviewing Western blot images included in the antibody testing data in our catalog, including those provided by third parties. Unless expressly labeled or annotated as “raw-unedited”, Western blot images included in the antibody testing data in our catalog may have been edited, optimized or otherwise adjusted for presentation.
产品信息
MA5-29235
种属反应
宿主/亚型
分类
类型
克隆号
抗原
偶联物
形式
浓度
规格
纯化类型
保存液
内含物
保存条件
运输条件
RRID
产品详细信息
This product is preservative free. It is recommended to add sodium azide to avoid contamination (final concentration 0.05%-0.1%).
This antibody has specificity for Human ENO2.
靶标信息
Neuron specific enolase (NSE, ENO1, ENO2, ENO3) is an enzyme that catalyzes the conversion of 2-phosphoglycerate to phosphoenolpyruvate in the glycolytic pathway, and the reverse reaction in gluconeogenesis. NSE has a high stability in biological fluids and can easily diffuse to the extracellular medium and cerebrospinal fluid (CSF) when neuronal membranes are injured.NSE is one of three mammalian enolases, which are also known as ENO1, ENO2, and ENO3 or alternately as enolase alpha, beta and gamma. The alpha-subunit is expressed in most tissues, the beta-subunit only in muscle, and the gamma-subunit is expressed primarily in neurons, in normal and in neoplastic neuroendocrine cells. Co-expression of NSE and chromogranin A is common in neuroendocrine neoplasms. Since neurons require a great deal of energy, they are very rich in glycolytic enzymes such a GAPDH and NSE. Antibodies to NSE protein are useful to identify neuronal cell bodies, developing neuronal lineage and neuroendocrine cells. Release of NSE from damaged neurons into CSF and blood has also been used as a biomarker of neuronal injury. NSE is used clinically as a sensitive and useful marker of neuronal damage in several neurological disorders including stroke, hypoxic brain damage, status epilepticus, Creutzfeldt-Jakob disease, and herpetic encephalitis. Further, NSE is found in elevated concentrations in plasma and certain neoplasias that include pediatric neuroblastoma and small cell lung cancer.
仅用于科研。不用于诊断过程。未经明确授权不得转售。
篇参考文献 (0)
生物信息学
蛋白别名: 2-phospho-D-glycerate hydro-lyase; Eno; ENOG; Enolase 2; gamma enolase; Gamma-enolase; Neural enolase; neuron specific enolase; Neuron-specific enolase; Neuronal Enolase; NSE
基因别名: ENO2
Entrez Gene ID: (Human) 2026